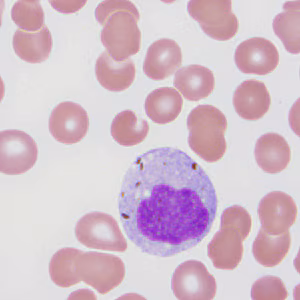

Case #287 – November, 2010
A 29-year-old pregnant woman from Ethiopia presented to a hospital with nausea, vomiting, abdominal pain and episodic fever. The symptoms started within a day after arriving in the United States, and had persisted for five days prior to hospitalization. Given her country of origin, blood specimens were collected in EDTA for malaria screening. She reported having been treated for malaria approximately one year prior (medications unknown). Images were captured from a Wright-stained thin blood smear at 1000x magnification and sent via email to the DPDx Team for diagnostic assistance. Figures A–D show four of the images sent to DPDx. What is your diagnosis? Based on what criteria?

Figure A

Figure B
Figure C

Figure D
This case and images were courtesy of the University of Texas HSC, San Antonio, TX.
Images presented in the DPDx case studies are from specimens submitted for diagnosis or archiving. On rare occasions, clinical histories given may be partly fictitious.
DPDx is an educational resource designed for health professionals and laboratory scientists. For an overview including prevention, control, and treatment visit www.cdc.gov/parasites/.